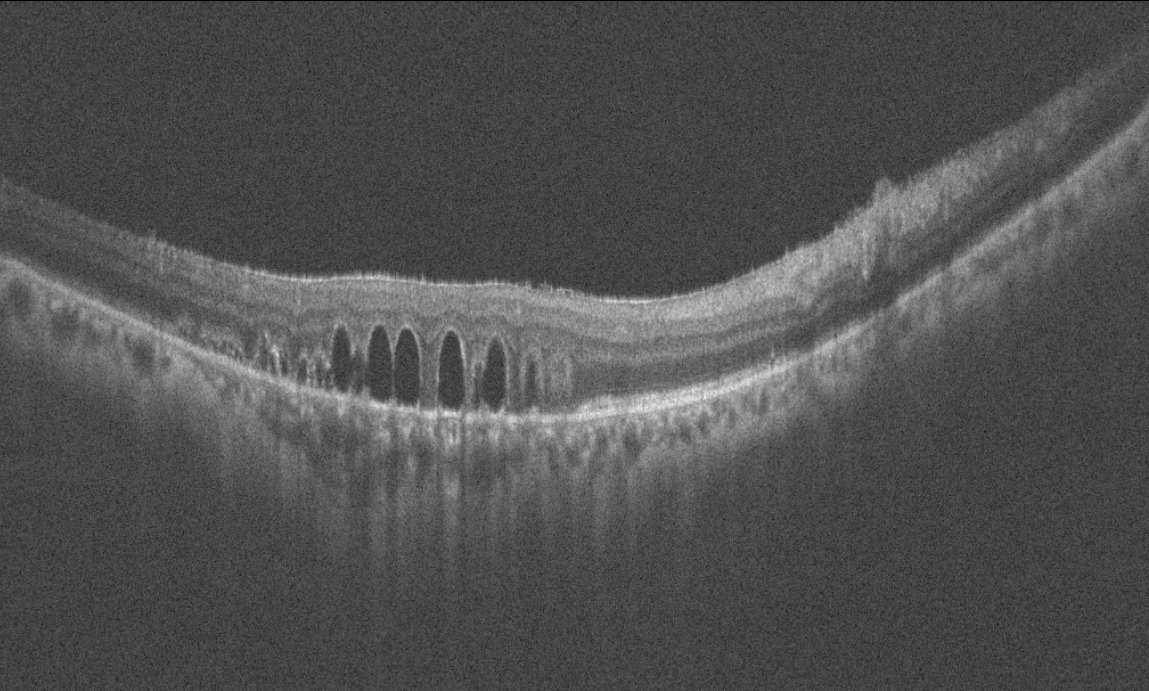

2025 Ekim Ayın Sorusu
Okuma:677
Sağ gözde görme keskinliği 0,3 düzeyinde olan 60 yaşındaki erkek hasta görme azlığı şikayeti ve retina bulguları nedeniyle kliniğimize refere edilmiştir. Hastanın başka bir klinikte 1 yıl önce retina cerrahisi geçirme öyküsü mevcuttur. Hastanın sağ göz renkli fundus, floresein anjiyografi ve optik koherens tomografi görüntülerini görmektesiniz. Bu bulgulara göre tanınız ve resimde fark edilen bulgu nedir? Lütfen cevabınızı aşağıya yazınız.
Ayın sorusunu bizimle paylaşan Dr. Mehmet Yasin TEKE’ye katkıları için teşekkür ederiz.
2025 Ekim Ayın Sorusu Cevap
Bu ay size sağ gözünde görme keskinliği 0,3 düzeyinde olan, 1 yıl önce geçirilmiş retina cerrahisi öyküsü bulunan, 60 yaşındaki erkek hastanın renkli fundus, floresein anjiyografi ve optik koherens tomografi görüntüleri eşliğinde tanısını ve retina bulgusunu sormuştuk.
Tanı: Retina dekolman cerrahisi sonrası retina altında kalmış olan sıvı perflorokarbon (dekalin-Perflorodekalin) damlacıkları’dır.
Sıvı perflorokarbonlar (PFK) hidrojen atomlarının flor atomları ile yer değiştirdiği florlanmış sentetik hidrokarbon analoglarıdır. Altı karbondan büyük olan perflorokarbonlar sıvı haldedir.
PFK’lar retinayı üçüncü bir el gibi fikse eden intraoperatif tamponatlardır. Tamponat gücü silikondan 6 kat fazladır. PFK renksiz, kokusuz, optik yönden saydamdır. Kırma indeksi suya yakındır ve optik aberasyon olmaksızın vitrektomide kullanılır. Özgül ağırlığı sudan yaklaşık 2 kat yüksektir. Bu sayede retinayı yatıştırır ve subretinal sıvıyı öne iterek periferik yırtıktan vitreusa geçmesini sağlar.
Yüzey gerilimi yüksek olduğu için tek bir parça halinde kalabilir ve retina altına kolayca kaçmaz. Viskositesi düşük olduğu için göz içine ince bir kanülle verilebilir. Alınması kolaydır. Kaynama noktası yüksek olduğu için buharlaşma olmadan laser yapılabilir. Laser dalga boylarını absorbe etmez. Perflorodekalin; refraktif indeksi 1.31 olup suya yakındır. Perflorodekalin ile sıvılar arası yüzey daha zor gözlenir. Viskositesi 2.7 olup perfloro-n-octane’dan daha yüksektir. Böylece daha güçlü bir bası sağlar ama verilip alınması daha zordur.
PFK sıvıları intraoperatif kullanımda güvenilir olmasına karşın oküler toksisite ve küçük parçalara ayrılma nedeniyle uzun süre gözde bırakılmamalıdır. Kimyasal toksisite, birleşiminde hidrojen varlığı gibi saflığın az olduğu durumlarda ortaya çıkar. Bu durumda lipoproteinlerin absorbsiyonu artmakta, fibroblastik reaksiyon tetiklenerek preretinal membranlar gelişmektedir. Göz içerisinde uzun süre kaldığında retina sinir lifi katında vakuoller, dış pleksiform tabakada psödomyelin birikimi, fotoreseptörlerde kısalma gözlenir.
Retina alt katında hasar çok daha fazla olduğu için burada kimyasal toksisiteden çok mekanik hasar düşünülür. PFK sıvıları jet akımla verildiğinde retina altına gidebilir ve küçük parçacıklar halinde bir bölgede kalabilir. Fovea altına gittiğinde fotoreseptörlere toksiktir ve alınması gereklidir.
Ayın sorusuna web sitesi aracılığıyla doğru cevap verenler arasında yapılan kura çekimi sonrası kitap ödülünü Sn. Dr. Erdem Topsakal kazanmıştır. Kendilerini tebrik ederiz.
Kitap ödülünün temin ve dağıtımında koşulsuz destekleri için DEVA Holding’e teşekkür ederiz.